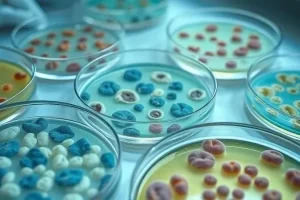

Замечали ли вы странные пятна на листьях ваших комнатных растений? Может быть, стебли стали мягкими и потемнели? Это могут быть признаки бактериальной инфекции. Бактериальные инфекции растений – распространенная проблема, с которой сталкиваются цветоводы. По статистике, около 15% комнатных растений подвержены бактериозам. К счастью, при своевременной диагностике и правильном лечении, большинство растений можно спасти. В этой статье мы подробно рассмотрим, как распознать, лечить и предотвратить бактериальные инфекции ваших зеленых питомцев.
Что такое бактериальные инфекции
Бактериальные инфекции растений – это заболевания, вызываемые патогенными бактериями. Эти микроорганизмы проникают в ткани растения через повреждения, устьица или раны, и начинают активно размножаться, вызывая различные симптомы. Существует множество видов бактерий, способных поражать растения, наиболее распространенные из них относятся к родам Pseudomonas, Xanthomonas, Agrobacterium, Erwinia и Corynebacterium. Развитие инфекции зависит от множества факторов, включая вид бактерии, состояние растения и условия окружающей среды.
Признаки бактериальных инфекций
Распознать бактериальную инфекцию на ранней стадии может быть сложно, но внимательный осмотр растений поможет выявить первые признаки. Симптомы могут варьироваться в зависимости от вида бактерии и пораженного растения, но есть общие признаки, на которые стоит обратить внимание:
- Появление водянистых пятен на листьях, которые со временем могут темнеть и отмирать.
- Потемнение и размягчение стеблей, часто сопровождающееся выделением слизи.
- Образование гнилей на корнях, приводящее к увяданию и гибели растения.
- Появление наростов или язв на стеблях и листьях.
- Изменение цвета и формы цветков.
- Неприятный запах от пораженных тканей.
- Пожелтение и опадение листьев.
- Замедленный рост и общее угнетение растения.
Пример из личного опыта: Однажды я заметил странные маслянистые пятна на листьях моей бегонии. Сначала я подумал, что это недостаток питательных веществ, но пятна быстро распространялись и листья начали отмирать. После консультации со специалистом я понял, что это бактериальный ожог, и вовремя начал лечение.
Причины возникновения
Бактериальные инфекции не возникают на пустом месте. Существует ряд факторов, которые способствуют развитию этих заболеваний:
- Неправильный уход: Недостаточный или избыточный полив, недостаток света, неправильный состав почвы.
- Переувлажнение: Постоянно влажная почва создает благоприятную среду для развития бактерий.
- Повреждения: Механические повреждения листьев и стеблей открывают путь для проникновения бактерий.
- Слабый иммунитет: Растения, ослабленные стрессом, болезнями или вредителями, более восприимчивы к инфекциям.
- Зараженные инструменты: Использование нестерилизованных инструментов при обрезке или пересадке растений.
- Зараженные растения: Приобретение растений с уже существующей инфекцией.
- Плохая вентиляция: Застой воздуха способствует развитию бактерий.
- Высокая влажность: Особенно в сочетании с теплой температурой.
Диагностика
Для точной диагностики бактериальной инфекции необходимо провести ряд исследований:
- Визуальный осмотр: Внимательно осмотрите растение на наличие характерных симптомов.
- Микробиологические исследования: Взятие образца пораженной ткани и посев на питательную среду для выделения и идентификации бактерии.
- Лабораторные анализы: Проведение ПЦР-диагностики для выявления ДНК бактерии.
Пример из личного опыта: Я всегда стараюсь проводить микробиологические исследования, когда не могу точно определить причину заболевания моего растения. Это позволяет мне выбрать наиболее эффективный метод лечения.
Лечение
Лечение бактериальных инфекций может быть сложным, но при своевременном вмешательстве можно спасти растение:
- Удаление пораженных частей: Обрежьте и уничтожьте все пораженные листья, стебли и корни.
- Антибиотики: Использование антибиотиков, таких как стрептомицин или тетрациклин, может быть эффективным, но требует осторожности и соблюдения дозировки.
- Фунгициды: Некоторые фунгициды обладают бактерицидным действием и могут помочь в борьбе с инфекцией.
- Народные средства: Раствор марганцовки, перекиси водорода или чеснока может помочь в борьбе с бактериями.
Пример из личного опыта: Я однажды успешно вылечил бактериальный ожог на моей герани, используя раствор марганцовки. Важно регулярно обрабатывать растение и соблюдать меры предосторожности.

Профилактика
Профилактика – лучший способ защиты ваших растений от бактериальных инфекций:
- Карантин: Новые растения необходимо помещать на карантин на 2-3 недели, чтобы убедиться в отсутствии признаков заболевания.
- Дезинфекция: Регулярно дезинфицируйте инструменты для обрезки и пересадки растений.
- Правильный уход: Обеспечьте растениям оптимальные условия выращивания, включая правильный полив, освещение и вентиляцию.
- Укрепление иммунитета: Регулярно подкармливайте растения, чтобы повысить их устойчивость к болезням.

Типичные ошибки
При лечении бактериальных инфекций цветоводы часто допускают ошибки, которые могут усугубить ситуацию:
- Неправильная диагностика: Неверное определение причины заболевания может привести к неэффективному лечению.
- Использование неподходящих препаратов: Не все антибиотики и фунгициды эффективны против всех бактерий.
- Недостаточная обработка: Неполное удаление пораженных частей растения может привести к повторному заражению.
- Игнорирование профилактических мер: Отсутствие карантина и дезинфекции инструментов увеличивает риск заражения.
Восстановление после болезни
После лечения важно помочь растению восстановиться:
- Обеспечьте оптимальные условия: Обеспечьте растению достаточно света, тепла и влаги.
- Подкормка: Подкармливайте растение комплексными удобрениями для восстановления сил.
- Наблюдение: Внимательно следите за состоянием растения, чтобы вовремя заметить признаки повторного заражения.
FAQ
Вопрос: Что делать, если бактериальная инфекция быстро распространяется?
Ответ: Немедленно изолируйте пораженное растение от других и начните лечение.
Вопрос: Можно ли использовать антибиотики для лечения бактериальных инфекций растений?
Ответ: Да, но только под контролем специалиста и с соблюдением дозировки.
Вопрос: Как предотвратить заражение бактериальными инфекциями?
Ответ: Соблюдайте карантин, дезинфицируйте инструменты и обеспечьте растениям правильный уход.